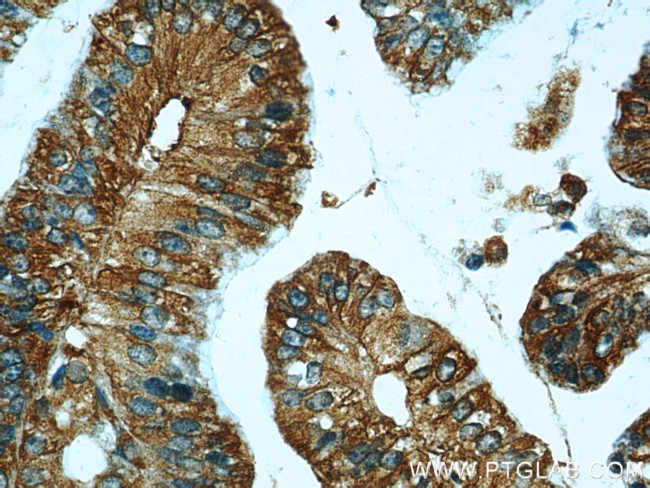
CCR2a Antibody in Immunohistochemistry (Paraffin) (IHC (P))

Search
Proteintech
CCR2a Polyclonal Antibody
{{$productOrderCtrl.translations['antibody.pdp.commerceCard.promotion.promotions']}}
{{$productOrderCtrl.translations['antibody.pdp.commerceCard.promotion.viewpromo']}}
{{$productOrderCtrl.translations['antibody.pdp.commerceCard.promotion.promocode']}}: {{promo.promoCode}} {{promo.promoTitle}} {{promo.promoDescription}}. {{$productOrderCtrl.translations['antibody.pdp.commerceCard.promotion.learnmore']}}
产品信息
16153-1-AP
种属反应
已发表种属
宿主/亚型
分类
类型
抗原
偶联物
形式
浓度
规格
纯化类型
保存液
内含物
保存条件
运输条件
产品详细信息
This antibody 16153-1-AP is raised against the peptide of 344-358 amino acids of CCR2a. It is specific to CCR2a.
靶标信息
CCR2, a chemokine receptor, is a regulator of monocyte/macrophage traffickings and is upregulated in response to inflammation. Resistance to HIV-1 infection or delayed progression to AIDS may be linked to CCR2 polymorphisms. The ligand for CCR2 is monocyte chemoattractant protein (MCP-1), a chemokine produced by endothelial cells, smooth muscle cells, and macrophages. Activation of monocytes by MCP-1 may mediate the monocytic infiltration of tissues in atherosclerosis and other inflammatory disorders including rheumatoid arthritis, alveolitis, and tumor infiltration. Two isoforms are produced by alternative splicing. CCR2 has been reported to be expressed in a wide variety of tissues, including blood, brain, heart, kidney, liver, lung, ovary, pancreas, spinal cord, spleen, thymus, and vessel. Increased expression of CCR2 has been documented in CD3+ lymphocytes in rheumatoid arthritis. ESTs have been isolated from liver/spleen and prostate libraries.
仅用于科研。不用于诊断过程。未经明确授权不得转售。
生物信息学
蛋白别名: C-C chemokine receptor type 2; C-C CKR-2; Cc-ckr2; CD192; CD192 antigen; chemokine (C-C motif) receptor 2; hCG_14621; MCP-1 receptor; MCP-1-R; Mcp1 receptor; Mcp1r; Monocyte chemoattractant protein 1 receptor; monocyte chemotactic protein 1 receptor; unnamed protein product
基因别名: CC-CKR-2; CCR-2; CCR2; CCR2A; CCR2B; CD192; CKR2; CKR2A; CKR2B; CMKBR2; MCP-1-R; PCLUD
UniProt ID: (Human) P41597
Entrez Gene ID: (Human) 729230